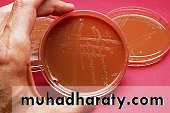
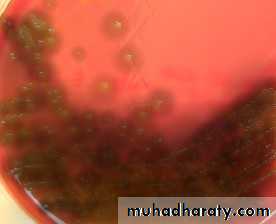
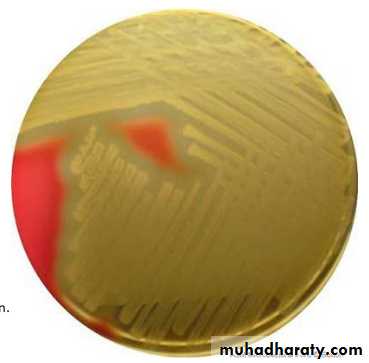
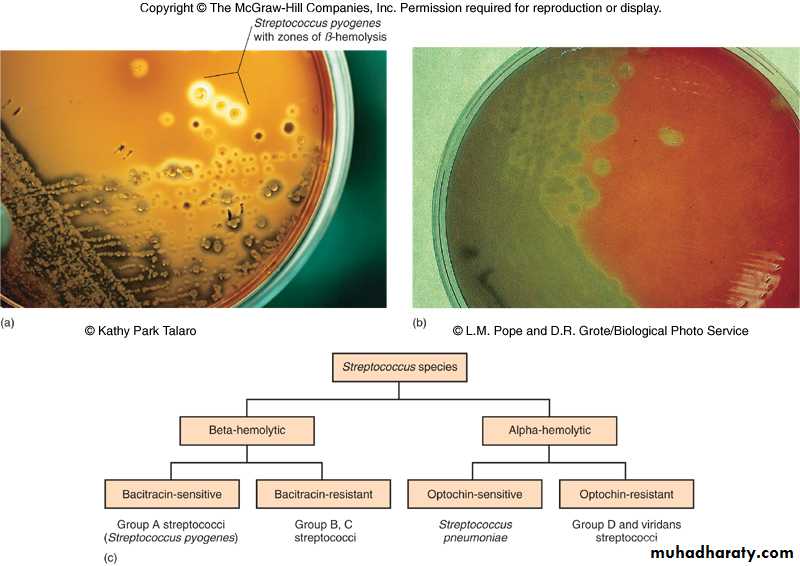
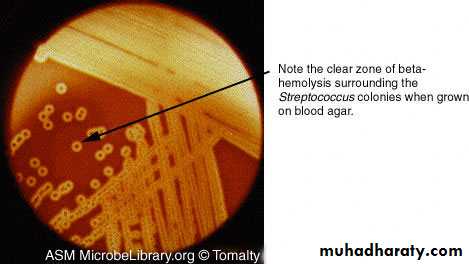
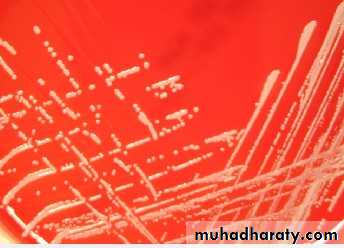
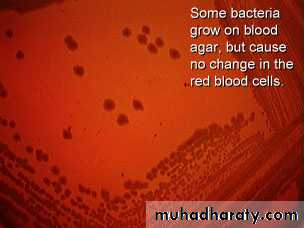
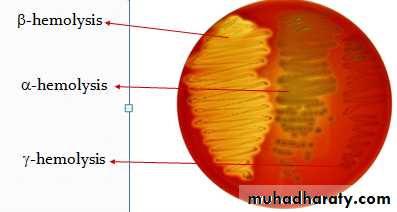
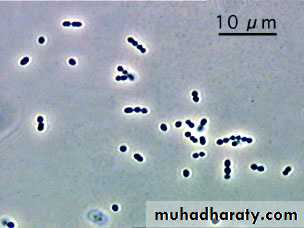
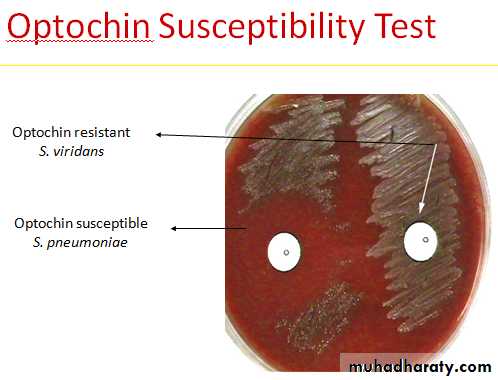

Bacteriology
Systemic BacteriologyPyogenic cocci
Streptococcus
By
Dr.Sanaa Khudur
PhD Medical Microbiology
Objective : Pyogenic cocci
Genus StreptococcusObjective : morphology
Antigenic structure
Pathogenicity
Members of this genus are widely distributed in environment, some are non pathogenic and could be a part of normal flora present in pharynx, mouth, intestine and female genital tract.
Others are pathogenic from simple to complex.
Membrane of this group are non motile, non spore forming, some are capsulated.
General Characteristics of Genus Streptococci
Gram-positive spherical/ovoid cocci arranged in long chains; commonly in pairs
Non-spore-forming, non motile
Can form capsules and slime layers
Facultative anaerobes
Do not form catalase
Most forms are fastidious and require enriched media.
Small, nonpigmented colonies
Sensitive to drying, heat and disinfectants
Culture characters:
Growth occur only in enriched media, majority are
facultative i.e. can grow under aerobic or anaerobic conditions grow at 37c but is aided by 5-10% co2. Few are obligatory anaerobic e.g peptostreptococcus.
Nutritionally streptococci are fastidious m.o. and only grow
on enriched media for example blood agar, chocolate agar and can’t grow on simple media like nutrient agar, it arranged in chains or in pairs.
Blood agar
chocolate agar
Classification of Streptococcus:
Specific criteria are used in classification of Streptococci
1. Type of growth on blood agar medium.
2. Serologic specificity.
3. Biochemical and physiological factors.
4. Capsular polysaccharide.
Type of growth on blood agar
1. β-hemolytic Streptococci: clear zones of hemolysis around the colonies.
2. α – hemolytic Streptococci : partial or incomplete hemolysis around the colony ex. Viridans streptococci , Streptococcus pneumoniae.
3. γ type of hemolysis ( Non hemolytic) streptococci : no change on surface of blood agar.
Group β streptococci is the most important group of Streptococci.
Hemolysis on blood agar
1- -hemolysis
Partial hemolysis
Green discoloration around the colonies
e.g. non-groupable Streptococci (S. pneumoniae & S. viridans)
-hemolysis
2- -hemolysisComplete hemolysis
Clear zone of hemolysis around the colonies
e.g. Group A & B (S. pyogenes & S. agalactiae)
-hemolysis
3--hemolysisNo lysis
e.g. Group D (Enterococcus spp)
-hemolysis
Types of hemolysis of Streptococci on Blood agar
Antigenic structure of hemolytic streptococci:-1. Carbohydrate antigen ( C antigen):
Its group specific cell wall antigen which is carbohydrate in
nature and it’s located in the cell wall of many streptococci and form the basis of serologic grouping (Lancefield grouping). On basic of this antigen β-hemolytic Streptococci are divided in to groups from A-U except I and J
A B C D E F G H K L M N O P Q R S T U (Lancefield groups)
Group A Streptococci (streptococcus pyogenes)
Is the most important human pathogen it can cause
pharyngitis , tonsillitis.
Group B Streptococci (Streptococcus agalaectiae )
Normal flora of female genital tract and can cause neonatal
sepsis and meningitis.
Group D streptococci include: -
Non Enterococci
Enterococcus e.g Enterococcus faecalis it resist bile ,6.5% Nacl and penicillin G.
Classification based on C- carbohydrate antigen of cell wall .
Groupable streptococci A, B and D (more frequent).
Non-groupable streptococci ,S. pneumoniae (pneumonia),viridans streptococci e.g. S. mutans causing dental carries
Cell structure of Streptococci bacteria
2. M- protein:It’s associated with virulence of group A streptococci. It’s
type specific and on basis of this antigen.
It appears as hair like projection of the cell wall, it help the bacteria to resist phagocytosis.
Immunity to infection with group A Streptococci is related to the presence of special Ab. But because there are approximately 80 type of M proteins, explain the repeatative infection with group A streptococci having different types of M proteins.
3. T substance:
This antigen has no relation to the virulence of Streptococci.
T-substance is acid labile and heat labile and it’s obtained from Streptococci by proteolytic digestion.
On basis of this antigen certain types of Streptococci are differentiated by agglutination. It’s type specific, permits differentiation of certain types of Streptococci. It’s used in epidemiological studies as “typing marker”.
4. Nucleoprotein:
Antigens associated with streptococcal cell body.
Group A streptococci (streptococcus pyogenes)
Is the most important human pathogen it can cause
pharyngitis , tonsillitis.
Most serious streptococcal pathogen
Strict parasite
Inhabits throat, nasopharynx, occasionally skin ,affect all ages peak incidence at 5-15 years of age
90% of cases of pharyngitis
The microscopical appearance of this bacteria is Gram positive cocci arrange in long chains.
The type of hemolysis of this bacteria on blood and chocolate agar is β-hemolytic.
The microscopical appearance of Group A streptococci (streptococcus pyogenes) Gram positive cocci arrange in long chains.
Toxins and enzymes (Virulence Factors )of group A Streptococci (Extracellular product):
Hemolysins (streptolysins) streptolysins – hemolysins; streptolysin O (SLO) and streptolysin S (SLS) – both cause cell and tissue injuryHemolysins: β- hemolytic Streptococci elaborate 2 hemolysins:
1. Streptolysin O *sensitive to oxygen
* antigenic ASO
Streptolysin O is a protein that is hemolytically active in the
reduced state but rapidly inactivated in the presence of oxygen its antigenic and combines quantitively with antistreptolysin O (ASO)this antibody blocks hemolysis by streptolysin O.
Streptolysin O +RBCs = hemolysis
Streptolysin O+ASO+ RBCs = no hemolysis
The ASO titer can be applied in the diagnosis of streptococcal infections.
Serum titer >200 I.U. is considered abnormal.
2. Streptolysin S * Not sensitive to oxygen
* Not an antigenic
It’s responsible for hemolysis around streptococcal colonies on blood agar surface.
Streptokinase (fibrinolysin).
Streptodornase (DNase).
Hyaluronidase (spreading factor).
Erythrogenic toxin (pyogenic toxin) induces fever and typical red rash
Pathogenesis and Virulence Factors
Structural components(Produces surface antigens)
M protein M, which interferes with opsonization and lysis of the bacteria,protect against lysozyme.
Lipoteichoic acid & F protein adhesion
Hyaluronic acid, which acts to camouflage the bacteria
Enzymes
Streptokinases
Deoxynucleases facilitate the spread of streptococci through tissues
C5a peptidase
Pyrogenic toxins that stimulate macrophages and helper T cells to release cytokines
Streptolysins
Streptolysin O lyse red blood cells, white blood cells, and platelets
Streptolysin S
Disease caused by Streptococcus pyogenes:
Can be divided into two groups:
1. Suppurative infection (pus forming).
2. Non suppurative sequelae.
Suppurative infection include:-
Pharyngitis (“strep throat”)-inflammation of the pharynx most common in infants and small children there is extensionsurrounding tissue causing otitis media,mastoiditis, meningitis. The tonsils are usually enlarged with enlarged tender cervical lymph nodes.
Infection can involve URT causing pneumonia which most commonly occur after viral infection.
Erysipilas: which is spreading infection of the skin or mucous membrane usually seen on the face. pathogen enters through a break in the skin and eventually spreads to the dermis and subcutaneous tissues; can remain superficial or become systemic
Surgical wound infection.
Purpural sepsis: Streptococcus enter the uterus after delivery causing purpural fever.
Scarlet fever fever-rash that begins on the chest and spreads across the body.
Streptococcus toxic shock syndrome.
Streptococcus Pyoderma-confined, pus-producing lesion that usually occurs on the face, arms, or legs.
Non suppurative infection
Post Streptococcus disease
1. Acute rheumatic fever.
2. Acute glomerulonephritis.
Rheumatic fever: : Life threatening inflammatory disease that leads to damage of heart valves muscle
Certain strain of group A hemolytic streptococci with cell
membrane antigen, this cross react with human heart muscles producing Ab which react with human heart muscles and valves, it is a hypersensitivity response.
Acute glomerulonephritis
Immune complex disease of kidney inflammation of the glomeruli and nephrons which obstruct blood flow through the kidneys occurs after skin infection or after pharyngitis by two to three weeks, certain GAHS type known as nephritogenic strain causing Nephritis initiated by (antigen- antibody) complex on the glomerular basement membrane. Symptoms include migratory arthritis, and carditis .
Group B: Streptococcus agalactiae
Regularly resides in human vagina, pharynx and large intestine.
Can be transferred to infant during delivery and cause severe infection.
Most prevalent cause of neonatal pneumonia, sepsis, and meningitis.
Pregnant women should be screened and treated.
Wound and skin infections and endocarditis in debilitated people.
The microscopical appearance of Group B Streptococci (streptococcus agalactia) Gram positive cocci arrange in short chains or pairs.
Differentiation between -hemolytic Streptococci
The following tests can be used to differentiate between -hemolytic StreptococciLanciefield Classification.
Bacitracin susceptibility Test Specific for S. pyogenes (Group A).
CAMP test Specific for S. agalactiae (Group B).
Bacitracin sensitivity
Principle:
Bacitracin test is used for identification of group A
To distinguish between S. pyogenes (susceptible to B) & S. agalactiae (Resistant to B)
Bacitracin will inhibit the growth of gp A Strep. pyogenes giving zone of inhibition around the disk
Procedure:
Inoculate blood agar plate( BAP) with heavy suspension of tested organism
Bacitracin disk (0.04 U) is applied to inoculated BAP
After incubation, any zone of inhibition around the disk is considered as susceptible
Group D Enterococci and Groups C and G Streptococci
Enterococcus faecalis, E. faecium, E. duransnormal colonists of human large intestine
cause opportunistic urinary, wound, and skin infections, particularly in debilitated persons
Bacteriology
α – hemolytic StreptococciIt includes:
1. Viridans streptococci
2. Streptococcus pneumoniae
Viridans streptococci
This microorganism has low virulence and often colonize in
the URT.
They considered as commensal m.o of the mouth and they can act as opportunistic pathogen and attack tissue. It is associated with dental caries and they are the leading cause of subacute bacterial endocarditis (SBE) following dental extraction it include:
These m.o. lack group specific carbohydrate in their cell wall.
Streptococcus pneumonia
All pathogenic strains form large capsules – major virulence factor.Specific soluble substance (SSS) varies among types.
84 capsular types have been identified
Causes pneumonia and otitis media
Also called Diplococcus pneumoniae or pneumococcus.
Normal inhabitant of the upper respiratory tract (URT) of human i.e. 40%-70% of normal individuals are carriers of these bacteria.
No animal reservoir, i.e. transmission is from infected to normal persons by direct route.
Some times may cause important human diseases such as pneumonia, bronchitis, sinusitis, otitis media and less frequently it invades blood stream producing bacteremia, and the most important complication of bacteremia includes: meningitis and septic arthritis.
Characteristics
- Gram positive young culture
- Lancet shaped diplococci, the adjacent sides are blunt, while the distal sides (ends) are pointed.
- Capsulated possessing a polysaccharide capsule.
- In sputum or pus, the bacteria are found singly sometimes, or forming short chains not exceeding 3 pairs in each chain.
- Gram negative in old culture and later on spontaneously will lyse due to autolytic activity and finally we can find gram negative debris, no intact cells are found in the culture.
Such lysis can be enhanced by surface active agent (bile
salts).
This phenomenon can be used to differentiate it from
other bacteria by adding 10% bile salts to young culture, well notice that the culture will become clear and the turbidity is gone, this is called bile solubility test.
Cultural:
-Facultative anaerobic.-Don’t grow on simple laboratory media (fastidious) i.e. requires enriched media.
- On blood agar they produce small colonies surrounding by α type of hemolysis.
Differentiation between Diplococcus pneumoniae and α-
haemolytic Streptococci
Bile solubility test
Principle:
S. pneumoniae produce a self-lysing enzyme to inhibit the growth
The presence of bile salt accelerate this process
Procedure:
Add ten parts (10 ml) of the broth culture of the organism to be tested to one part (1 ml) of 2% Na deoxycholate (bile) into the test tube
Negative control is made by adding saline instead of bile to the culture
Incubate at 37oC for 15 min
Record the result after 15 min
Results:
Positive test appears as clearing in the presence of bile while negative test appears as turbid
S. pneumoniae soluble in bile whereas S. viridans insoluble
2-Optochin Susceptibility Test
Optochin (ethylhydrocupreine hydrochloride) sensitivity test Sensitive Resistant3-Capsule swelling(Quellung reaction)
Quellung reaction test : Pneumococcus of certain type when mixed with anti- capsular antibodies on microscopic slide, the capsule swells markedly and can be visualized by examination of the slide under low power.capsule around the bacterial body
Antigenic structure of Diplococcus pneumoniae1. Capsular polysaccharide (specific soluble substance SSS)
- large polysaccharide polymers (pneumococcal capsule).
- Pneumococci are differentiated into 80 serological types on
basis of capsular polysaccharide.
Virulence Markers of Streptococcus pneumoniae associated with:
-Polysaccharide capsule which may prevent or delay
phagocytosis. Non capsulated pneumococci are avirulent (nonpathogenic).
- Production of IgA protease: this enzyme inactivate IgA which is the main secretary Ig in URT.
This enzyme aids the bacteria to colonize in the URT.
We inhale these bacteria continuously but they are
phagocytized this indicates that reparatory mucosa posses a
great natural resistant to Streptococci.
In some individuals such bacteria colonize in the mucosa of URT and these become carriers. If resistance becomes low, the bacteria invade the lung producing pneumonia.
Predisposing Factors:
1. Viral infection.
2. Abnormality of respiratory tract.
3. Trauma of pharynx.
4. Allergy.
5. Cough reflex.
6. Some change in movement of cilia.
7. Deep anaesthesia.
8. long bed rest.
From lung they may invade the blood stream producing
bacteremia.